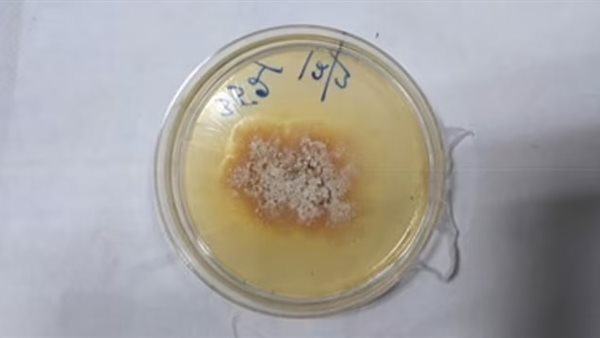
مرض الورقة الفضية

أعراضه تشبه الإنفلونزا.. رصد أول إصابة بشرية بمرض فطري قاتل في النباتات
أصيب صياد فطر هندي بمرض فطري قاتل للنباتات، ليسجل أول حالة إصابة في العالم بهذا النوع من الأمراض.
وعانى الصياد الهندي من أعراض تشبه أعراض الإنفلونزا، مع صعوبة في البلع لمدة 3 أشهر، وفقًا لـ ديلي ميل.
أول إصابة بشرية بمرض فطري قاتل في النباتات
طلب الرجل البالغ من العمر 61 عامًا المساعدة بعد معاناته من أعراض تشبه أعراض الإنفلونزا وصعوبة في البلع لمدة ثلاثة أشهر، وأجرى الأطباء فحوصات أظهرت أنه يعاني من خراج في القصبة الهوائية، وعندما حللوا عيناته اكتشفوا أنه مصاب بوربوريوم الغضروف، والذي تسببه فطريات موجودة في النباتات، ويطلق عليه مرض الأوراق الفضية في النباتات، وينتشر عن طريق الجراثيم المحمولة جوًا، وتحول أوراق النباتات إلى اللون المعدني قبل قتلها ببطء.
يُعتقد أنه أصيب بالعدوى أثناء إجراء بحث كطبيب فطري للنبات، والذي يتضمن العمل مباشرة مع العفن والخميرة والفطر، حيث كان الرجل يعمل مع مواد متحللة وفطر وفطريات نباتية مختلفة لفترة طويلة.

وأثار هذا حيرة الأطباء، لأنها تثبت أن العدوى يمكن أن تؤثر على الأفراد الأصحاء، وكذلك الأشخاص الذين يعانون من نقص المناعة.
وأشار الأطباء المعالجون للحالة إلى أن المريض حضر إلى المستشفى يشكو من سعال متكرر، وبحة في الصوت وإرهاق لم يتمكن من تغييره لمدة ثلاثة أشهر.
والجدير بالذكر أن مرض الورقة الفضية مرض فطري يصيب الخشب وأوراق بعض الأشجار وخاصة البرقوق والتفاح والمشمش والكرز، وهو ناتج عن مُمْرِض النبات chondrostereum purpureum وهو مرض تقدمي شائع وغالبًا ما يكون مميتًا.





















